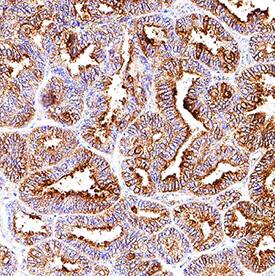
HSP27 antibody in Human Ovarian Cancer Tissue by Immunohistochemistry (IHC-P).

Human HSP27 Antibody
R&D Systems, part of Bio-Techne | Catalog # MAB15801


Key Product Details
Species Reactivity
Validated:
Cited:
Applications
Validated:
Cited:
Label
Antibody Source
Product Specifications
Immunogen
Met1-Lys205
Accession # P04792
Specificity
Clonality
Host
Isotype
Scientific Data Images for Human HSP27 Antibody
Detection of Human HSP27 by Western Blot.
Western blot shows lysates of MCF-7 human breast cancer cell line and HeLa human cervical epithelial carcinoma cell line. PVDF membrane was probed with 0.1 µg/mL of Rat Anti-Human HSP27 Monoclonal Antibody (Catalog # MAB15801) followed by HRP-conjugated Anti-Rat IgG Secondary Antibody (Catalog # HAF005). A specific band was detected for HSP27 at approximately 27 kDa (as indicated). This experiment was conducted under reducing conditions and using Immunoblot Buffer Group 1.HSP27 in HeLa Human Cell Line.
HSP27 was detected in immersion fixed HeLa human cervical epithelial carcinoma cell line using Rat Anti-Human HSP27 Monoclonal Antibody (Catalog # MAB15801) at 8 µg/mL for 3 hours at room temperature. Cells were stained using the NorthernLights™ 557-conjugated Anti-Rat IgG Secondary Antibody (red; Catalog # NL013) and counterstained with DAPI (blue). Specific staining was localized to cytoplasm. View our protocol for Fluorescent ICC Staining of Cells on Coverslips.HSP27 in Human Ovarian Cancer Tissue.
HSP27 was detected in immersion fixed paraffin-embedded sections of human ovarian cancer tissue using Rat Anti-Human HSP27 Monoclonal Antibody (Catalog # MAB15801) at 5 µg/mL overnight at 4 °C. Tissue was stained using the Anti-Rat HRP-DAB Cell & Tissue Staining Kit (brown; Catalog # CTS017) and counterstained with hematoxylin (blue). Specific staining was localized to cytoplasm and plasma membrane in epithelial cells. View our protocol for Chromogenic IHC Staining of Paraffin-embedded Tissue Sections.Applications for Human HSP27 Antibody
Immunocytochemistry
Sample: Immersion fixed HeLa human cervical epithelial carcinoma cell line
Immunohistochemistry
Sample: Immersion fixed paraffin-embedded sections of human ovarian cancer tissue
Western Blot
Sample: MCF‑7 human breast cancer cell line and HeLa human cervical epithelial carcinoma cell line
Formulation, Preparation, and Storage
Purification
Reconstitution
Formulation
Shipping
Stability & Storage
- 12 months from date of receipt, -20 to -70 °C as supplied.
- 1 month, 2 to 8 °C under sterile conditions after reconstitution.
- 6 months, -20 to -70 °C under sterile conditions after reconstitution.
Background: HSP27
Heat shock proteins (HSPs) are a family of highly conserved stress response proteins. Heat shock proteins function primarily as molecular chaperones by facilitating the folding of other cellular proteins, preventing protein aggregation or targeting improperly folded proteins to specific degradative pathways. HSPs are typically expressed at low levels under normal physiological conditions but are dramatically up-regulated in response to cellular stress. Elevated levels of HSPs have been observed in association with ischemia/reperfusion, cancer, and chronic heart failure. HSP27 is a member of the small heat shock protein family, which also includes HSP25 and the alpha-crystallins. Ser78 and Ser82 of HSP27 are phosphorylated in vivo in response to growth factors or heat shock, and the extent of phosphorylation plays a role in determining specific functions. HSP27 forms a large oligomer and functions as an anti-apoptotic molecule, regulating apoptosis through direct interaction with key components of the apoptotic pathway. HSP27 binds and sequesters cytochrome c released from the mitochondria in response to an apoptotic stimulus. This prevents the proper assembly of the apoptosome and subsequently, the activation of procaspase-9 and procaspase-3.
References
- Gusev, N.B. et al. (2002) Biochemistry (Moscow) 67:511.
- Garrido, C. et al. (2001) Biochem. Biophys. Res. Commun. 286:433.
- Garrido, C. (2002) Cell Death Diffr. 9:483.
- Brvey, J-M. et al. (2000) Nat. Cell Biol. 2:645.
Long Name
Alternate Names
Gene Symbol
UniProt
Additional HSP27 Products
Product Documents for Human HSP27 Antibody
Product Specific Notices for Human HSP27 Antibody
For research use only